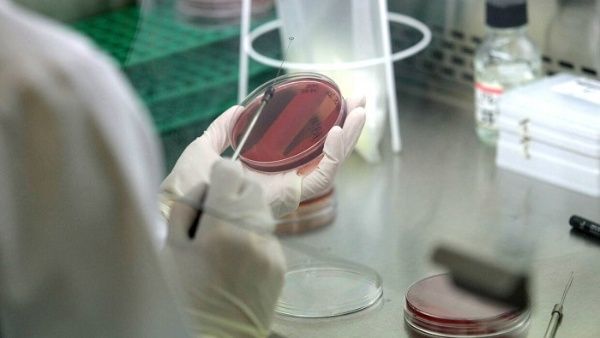
Brote de legionela deja al menos 19 muertos en Polonia

Rt/ En Polonia, autoridades sanitarias informaron este sábado que 19 personas murieron debido a un brote de legionela en la ciudad de Rzeszów, en el sureste del país europeo.
El Departamento de Sanidad de la urbe aseveró que “todos los fallecidos padecían dolencias previas” y cifró en unas 160 las personas contagiadas con esa bacteria.
Asimismo, se conoció que, de ese total, 107 corresponden solo a la ciudad de Rzeszów, urbe ubicada a 250 km al sur de Varsovia (capital), cabecera de la región administrativa de Subcarpatia y cercana a la frontera con Ucrania.
Durante una conferencia de prensa el jueves pasado, el inspector sanitario estatal de Subcarpatia, doctor Adam Sidor, declaró que muestras de agua tomadas los días 19 y 20 de agosto revelaron alta presencia de la bacteria Legionella.
No obstante, dijo que ello no permitió conocer la fuente de la infección masiva y que para eso se requiere una mayor investigación epidemiológica.
El experto valoró que la reducción de las infecciones durante las últimas jornadas podría indicar que el brote está desapareciendo, aunque dejó claro que para estar más seguros haría falta conocer el resultado de los análisis a muestras de agua tomadas en fecha más reciente.
La enfermedad de la bacteria Legionella pneumophila provoca síntomas parecidos a los de la gripe o neumonía grave, tales como fiebre, escalofríos y tos. Algunos pacientes presentan también dolores musculares, dolor de cabeza y cansancio, así como pérdida de apetito y, ocasionalmente, diarrea.
Las altas temperaturas favorecen la presencia de ese microorganismo y se contagia, habitualmente, a través de agua atomizada presente en las duchas, las fuentes públicas, los humidificadores o el sistema de agua.
Para evitar la concentración de esa bacteria en los edificios, lo más recomendable resulta realizar las limpiezas y desinfecciones periódicamente, sobre todo en establecimientos que llevan tiempo sin usarse.